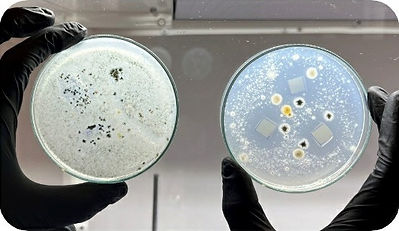

Rock the news
Green Tech last news
Metalchemy, a company based in London, has developed, through a green production process of silver-based nanoparticles, a system that increases the longevity of fresh food products, considerably increasing shelf life thanks to the most advanced and versatile intelligent packaging using materials that are completely biodegradable , biocompatible, and made from natural ingredients.
Tackling the Food Waste Crisis Metalchemy leverages advanced silver based technologies to extend the shelf life of products, aiming to significantly reduce food waste and its associated environmental footprint. By potentially saving 1.9-2.85 million tonnes of food annually in the UK alone, our technology could help feed approximately 1.6 million people each year from the saved resources. Metalchemy leverages advanced silver based technologies to extend the shelf life of products, aiming to significantly reduce food waste and its associated environmental footprint.
​
Unique Benefits of Our Silver Ag+ Packaging Technology

1. Increased Shelf Life
Antimicrobial, antioxidant and natural coatings can increase the shelf life of highly perishable and valuable products, from food to health and cosmetics.
2. Versatile Integration
Metalchemy tailor to specific coatings & concentrations to fit our client needs, using ethical green manufacturing processes and no animal testing within a wide range of packaging materials.
3. Food Safety Certified
Packaging technology is fully food safety certified by our external partner, Eurofins, a ISO 90001 and ISO 17025 testing compliant laboratory, ensuring rigorous testing and compliance.
4. Green Manufacturing
Produced sustainably using our patented process all our products are vegan, vegetarian and with no animal testing. We follow ISO 9001:2015 standards within all of our facilities.
Powerful Patented Technology
​
Green silver technology embedded in synthetic and biomaterials exploits antimicrobial properties, effectively killing harmful bacteria, fungi, and viruses, thereby delaying food degradation.

